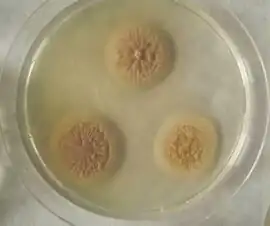
alternativní popis obrázku chybí

Acremonium chrysogenum
![]() Acremonium chrysogenum na Sabouradově agaru | |
| Vědecká klasifikace | |
| Říše | Fungi |
| Podříše | Dikarya |
| Oddělení | Ascomycota |
| Pododdělení | Pezizomycotina |
| Třída | Sordariomycetes |
| Podtřída | Hypocreomycetidae |
| Řád | Hypocreales |
| Čeleď | Hypocreaceae |
| Rod | Acremonium |
| Binomické jméno | |
| Acremonium chrysogenum | |
| Některá data mohou pocházet z datové položky. | |
Acremonium chrysogenum (syn. Cephalosporium acremonium) je mikroskopická vláknitá houba (mikromyceta) řadící se mezi Ascomycota [1]. Jedná se o aerobní mikroorganismus, žijící běžně v prostředí [2][3]. Významný je zejména díky své produkci antibiotika cefalosporinu C [4].
Taxonomické zařazení
Acremonium chrysogenum patří do říše Fungi, podříše Dikarya, phyla Ascomycota, podphyla Pezizomycotina, třídy Sordariomycetes, podtřídy Hypocreomycetidae, řádu Hypocreales, čeledi Hypocreaceae a rodu Acremonium [1]. Jelikož neustále dochází k reklasifikaci mikromycet, lze tuto mikromycetu nalézt i pod starším názvem Cephalosporium acremonium [5].
Obecná charakteristika
Acremonium chrysogenum roste dobře na obecných mikromycetních růstových médiích při teplotě okolo 25 – 30 °C [6][3]. Vyznačuje se osamocenými akulovitými fialidy nebo lehce větvenými konidiofory, které vyrůstají z vegetativních hyf a nesou buď vlhký shluk, suché řetízky konidií nebo obojí [6][7]. Konidie bývají podlouhlé, 1 – 3 µm x 4 – 8 µm velké [3]. Hyfy mohou být někdy propleteny dohromady a tvořit provazy široké několik buněk v průměru [3][7]. V makroskopickém měřítku tvoří hyfy bělavé, nažloutlé, narůžovělé nebo nazelenalé ploché, hladké kolonie, které časem zarůstají uvolněnými hyfami a získávají práškovitou, semišovou, vločkovitou nebo vatovitou strukturu [6][3].
A. chrysogenum je převážně saprofyt žijící ve vlhkém prostředí, zároveň bylo ovšem potvrzeno, že se jedná o oportunního patogena, který může způsobovat infekce u rostlin a imunosuprimovaných obratlovců [8][9][10][11]. Nachází se v půdě, na rostlinných zbytcích a hnijících houbách [7][11]. Vlhké spory jsou šířeny větrem, na kapkách vody nebo pomocí hmyzu [3]. Často se také vyskytuje na stavebních materiálech na bázi celulosy (stropní desky, lepenka, dřevěné materiály), opět zejména ve vlhkém prostředí [11]. K degradaci celulosy a dalších sloučenin uhlíku potom dochází především působením extracelulárně produkovaných celulas a reaktivních forem kyslíku [11]. Navíc produkuje A. chrysogenum sloučeniny s Mn3+ a minerály oxidů Mn3+ a Mn4+, které jsou silnými oxidačními činidly a dále podporují degradaci polymerů uhlíku, zároveň s koloběhem kovů v prostředí [11]. Produkce těchto vysoce reaktivních sloučenin je růstově specifická, částečně závislá na buněčné diferenciaci, typu využívaného substrátu, typu sekretovaných proteinů a mezidruhové interakci v prostředí, přestože související molekulární mechanismy nejsou plně objasněny [11].
A. chrysogenum je aerobní organismus, zvýšené koncentrace kyslíku v médiu jsou kritické pro maximální produkci antibiotika cefalosporinu C [4][12]. Rozmnožuje se pohlavně [13], dlouhou dobu ovšem nebyl znám žádný sexuální stav nebo teleomorfní forma a vědělo se jen o asexuálním typu rozmnožování, proto bylo A. chrysogenum dříve zařazeno do skupiny imperfektních hub (Deuteromycetes) [3][14][15][16]. V roce 2008 byla ovšem provedena analýza transkriptomu A. chrysogenum a identifikována exprese dvou MAT genů (typ párování, ang. mating-type), přičemž byla nalezena i cDNA kódující domnělý feromonový receptor a enzymy signální dráhy feromonové odezvy [13].
Cefalosporin C

Biotechnologicky nejvýznamnějším metabolitem A. chrysogenum je antibiotikum cefalosporin C. Jedná se o β-laktamové antibiotikum, které inhibuje syntézu strukturálních komponent bakteriální buněčné stěny [17][18]. Často se používá jako alternativa u pacientů, kteří jsou senzitivní na penicilin [17]. V roce 2003 představovala β‑laktamová antibiotika (zejména peniciliny a cefalosporiny) hlavní světové biotechnologické produkty s celosvětovým ziskem z prodeje 15 miliard amerických dolarů a pokrývala 65 % celosvětového trhu s antibiotiky [4]. V roce 2017 byl celosvětový zisk z prodeje samotného cefalosporinu C 10 miliard [18].
Modifikací β-laktamového kruhu a postranního řetězce bylo připraveno více než 20 derivátů s řadou antibakteriálních vlastností [4][17]. Tyto deriváty byly uspořádány do skupin na základě jejich aktivity: cefalosporiny první generace (např. cefalothin) jsou širokospektrá antibiotika účinná proti grampozitivním i mnoha gramnegativním bakteriím, včetně rodů Staphylococcus, Streptococcus a mnoha kmenů Escherichia coli [17]. Cefalosporiny druhé (např. cefuroxim) a třetí (např. ceftazidim) generace bývají účinnější proti gramnegativním bakteriím, které se staly rezistentními vůči cefalosporinům první generace [17]. Cefalosporiny druhé generace jsou účinné například proti kapavce způsobené Haemophilus influenzae a abscesům způsobeným Bacteroides fragilis [17]. Schopnost mnoha cefalosporinových derivátů pronikat do mozkomíšního moku je také činí účinnými při léčbě meningitidy [17].
Biosyntetická dráha cefalosporinu C začíná ze tří důležitých produktů primárního metabolismu - aminokyselinových prekurzorů: L-cysteinu, L-valinu a L-α-aminoadipové kyseliny [19][20]. Kyselina α-aminoadipová je v A. chrysogenum nejen prekurzorem cefalosporinu C, ale také klíčovým meziproduktem biosyntetické dráhy aminokyseliny lysinu [21]. Cystein je pro biosyntézu cefalosporinu odvozen od methioninu přes reverzní transsulfurační dráhu pomocí cystationin-γ-lyasy [19][22]. Methionin je velmi důležitý nejen jako prekurzor pro cystein, ale také stimuluje transkripci genů pro enzymy biosyntetické dráhy cefalosporinu C a biosyntetickou dráhu reguluje [19]. Navíc bylo prokázáno, že má methionin vliv na morfologickou diferenciaci mycelia, která je spojená s produkcí cefalosporinu [20][23]. Biosyntetická dráha β-laktamových antibiotik dále pokračuje přes isopenicilin N, odkud se v A. chrysogenum ubírá směrem k cefalosporinu C, v jiných organismech v tomto bodě odbočuje k penicilinu G nebo cefamycinu N [19].
Biotechnologická produkce
Produkce cefalosporinu C je aerobní proces, který může být proveden konvenčně s volnými buňkami v tankovém bioreaktoru nebo nekonvenčně s buňkami imobilizovanými v náplňovém nebo airlift bioreaktoru [18]. V obou případech lze fermentaci provádět vsádkově, fed-batch i kontinuálně, vždy je ovšem kladen důraz na dostatečnou aeraci a míchání, jelikož je dostupnost kyslíku hlavním limitujícím faktorem procesu [4][18][2].
Velký vliv na produkci sekundárního metabolitu má samozřejmě fyziologický stav mikrobiální kultury [24]. Kromě toho ovšem záleží na velkém množství faktorů od typu substrátů po způsob kultivace. Bylo prokázáno, že suplementace hůře‑metabolizovatelným zdrojem uhlíku, jako je sójový olej, stimuluje produkci cefalosporinu C [4][20]. Využití takového substrátu je podstatně náročnější a vede k pomalejšímu růstu, kdy se vegetativní mycelium přeměňuje na mnohobuněčné stádium artrospor, které má za následek vyšší dostupnost kyslíku a produkci cefalosporinu C [4]. Velmi významný stimulační efekt na biosyntézu cefalosporinu C má methionin, zejména D‑isomer, přidaný do média [25][26]. Lepší stimulační aktivita D‑isomeru je důsledkem toho, že ho A. chrysogenum pomaleji přijímá a není tolik dostupný pro intracelulární degradaci [19]. Intracelulárně je D-isomer převáděn na L-formu [19].
Pro další zvýšení výtěžku produkce cefalosporinu C v A. chrysogenum byly uplatněny různé strategie, například navýšení počtu kopií genů pro enzymy biosyntetické dráhy cefalosporinu [4][12], případně transformace homologními geny z příbuzných organismů, jejichž produkty (enzymy biosyntetické dráhy cefalosporinu C) mají vyšší aktivitu [27]. Zvýšená produkce cefalosporinu C byla také pozorována po transformaci produkčního kmene DNA vektorem obsahujícím gen pro kyslík‑vazebný hemový protein [28] nebo po snížení aktivity H+-ATPasy na plasmatické membráně A. chrysogenum vedoucí ke zvýšenému množství ATP dostupného pro produkci cefalosporinu C [29].
Za zmínku také stojí, že limitujícím faktorem biosyntézy cefalosporinu C je nejen přísun aminokyselinových prekurzorů a kofaktorů z primárního metabolismu, ale také směřování centrálních metabolitů do metabolických drah vedoucích k biosyntéze těchto prekurzorů a kofaktorů [20][30].
Fermentační médium je navrženo tak, aby poskytovalo základní suroviny pro růst a produkci cefalosporinu C [18]. Jako zdroj uhlíku jsou využívány glukosa, fruktosa, sacharosa nebo laktosa spolu se složitějšími látkami jako výše zmiňovaný sójový olej nebo olej arašídový [4][18][20]. Kromě složitějších zdrojů uhlíku mohou morfologickou diferenciaci mycelia ovlivňovat i zdroje dusíku, např. močovina, kvasniční extrakt, kasein, dusičnany nebo amonné soli, které mohou rovněž pomoci s udržením optimálního pH v průběhu procesu [4][18][31]. Často se jako levný zdroj používá šrot ze sójových bobů nebo bavlníkových semen, případně kukuřičný výluh, který je rovněž bohatý na aminokyseliny, vitamíny, organické kyseliny a stopové prvky [4]. pH fermentace by mělo být udržováno mezi 6,2 a 7,0 a teplota mezi 24 °C a 28 °C [4][31]. Rozpuštěný kyslík by měl být udržován na 30 % nasycení a výše [4]. Pokud je potřeba, je možné přidat silikonový olej na zamezení pěnění [18].
Průběh kultivace je charakterizován rapidní spotřebou dobře využitelného zdroje uhlíku (sacharosy) na vytvoření biomasy v počátku procesu [18]. S postupem fermentace je tento dobře využitelný substrát spotřebován a je nahrazen složitějším, který navodí morfologickou diferenciaci a zvýšenou produkci cefalosporinu C [4][32]. S postupem fermentace je také nutné do bioreaktoru přidat chemické inhibitory a blokátory k zamezení interakcí surového cefalosporinu C s jinými sloučeninami, které by mohly vést k jeho znehodnocení [18]. Kritické jsou rovněž izolační a purifikační kroky, které začínají prudkým ochlazením média na 3 – 5 °C s následným odstraněním pevného mycelia filtrací nebo centrifugací [4][32]. Jedním z problémů bývá to, že na konci fermentace obsahuje médium kromě cefalosporinu C i malé množství jeho prekurzorů, například penicilinu N [4]. Účinné separace může být dosaženo například použitím aktivního uhlí nebo neionické pryskyřice, které přednostně adsorbují cefalosporin C před penicilinem N a dalšími kontaminujícími prekurzory [4]. Jiná izolační strategie zahrnuje modifikaci aminoskupiny cefalosporinu a jeho vykrystalizování za optimálních podmínek z okyseleného média [4]. Následně je doporučeno provést několik extrakčních kroků pro dosažení požadované čistoty produktu [4].
Výhled do budoucnosti
Dříve byl velký problém s nestabilitou surového cefalosporinu C, který se částečně rozpadal, a proto nebylo příliš možné a vhodné využívat kontinuální režim produkce [4]. Tento problém byl ovšem vyřešen zavedením methoxy skupiny do surového cefalosporinu C, která výrazně zvýšila jeho stabilitu [18]. Nyní pokračují vědci ve výzkumu snahou syntetizovat nové, semi-syntetické cefalosporiny a modifikovat stávající semi-syntetické cefalosporiny, aby se dostaly k molekulám odolným k β-laktamásám [18]. Stejně tak je snaha o syntézu rozpustnějších cefalosporinů a účinnější produkci cefalosporinových prekurzorů [18]. Velmi se také pracuje na optimalizaci kultivačních podmínek, například optimalizaci živení fermentačního procesu [32]. Výzkum se také zaměřuje směrem zlepšení aerace kultivačního procesu, kdy jsou pokusy o zvýšení přestupu kyslíku pomocí symbiotické imobilizace A. chrysogenum s řasami Chlorella pyrenoidosa [18].
Odkazy
Reference
- ↑ a b MYCOBANK Database. www.mycobank.org [online]. [cit. 2023-01-09]. Dostupné online.
- ↑ a b KOZMA, József; KARAFFA, Levente. Effect of oxygen on the respiratory system and cephalosporin-C production in Acremonium chrysogenum. Journal of Biotechnology. 1996-07, roč. 48, čís. 1–2, s. 59–66. Dostupné online [cit. 2023-01-07]. doi:10.1016/0168-1656(96)01400-9. (anglicky)
- ↑ a b c d e f g Acremonium spp.. INSPQ [online]. [cit. 2022-12-14]. Dostupné online. (anglicky)
- ↑ a b c d e f g h i j k l m n o p q r s t ELANDER, R. P. Industrial production of β-lactam antibiotics. Applied Microbiology and Biotechnology. 2003-06, roč. 61, čís. 5–6, s. 385–392. Dostupné online [cit. 2023-01-07]. ISSN 0175-7598. doi:10.1007/s00253-003-1274-y. (anglicky)
- ↑ Species Fungorum - Species synonymy. www.speciesfungorum.org [online]. [cit. 2023-01-07]. Dostupné online.
- ↑ a b c PERDOMO, H.; SUTTON, D. A.; GARCÍA, D. Spectrum of Clinically Relevant Acremonium Species in the United States. Journal of Clinical Microbiology. 2011-01, roč. 49, čís. 1, s. 243–256. Dostupné online [cit. 2022-12-14]. ISSN 0095-1137. doi:10.1128/JCM.00793-10. PMID 21068274. (anglicky)
- ↑ a b c GUARRO, J.; GAMS, W.; PUJOL, I. Acremonium Species: New Emerging Fungal Opportunists—In Vitro Antifungal Susceptibilities and Review. Clinical Infectious Diseases. 1997-11, roč. 25, čís. 5, s. 1222–1229. Dostupné online [cit. 2023-01-07]. ISSN 1058-4838. doi:10.1086/516098. (anglicky)
- ↑ FINCHER, Ruth-Marie E.; FISHER, John F.; LOVELL, Roger D. Infection Due to the Fungus Acremonium (Cephalosporium):. Medicine. 1991-11, roč. 70, čís. 6, s. 398–409. Dostupné online [cit. 2023-01-07]. ISSN 0025-7974. doi:10.1097/00005792-199111000-00005. (anglicky)
- ↑ FLEMING, Rhonda V; WALSH, Thomas J; ANAISSIE, Elias J. Emerging and less common fungal pathogens. Infectious Disease Clinics of North America. 2002-12, roč. 16, čís. 4, s. 915–933. Dostupné online [cit. 2023-01-07]. doi:10.1016/S0891-5520(02)00041-7. (anglicky)
- ↑ LIAO, W. Q.; XUE, Y. S.; CHEN, P. M. Cepholosporium acremonium. A new strain of fungus causing white piedra. Chinese Medical Journal. 1991-05, roč. 104, čís. 5, s. 425–427. PMID: 1879212. Dostupné online [cit. 2023-01-07]. ISSN 0366-6999. PMID 1879212.
- ↑ a b c d e f NORDBERG, Henrik; CANTOR, Michael; DUSHEYKO, Serge. The genome portal of the Department of Energy Joint Genome Institute: 2014 updates. Nucleic Acids Research. 2014-01, roč. 42, čís. D1, s. D26–D31. Dostupné online [cit. 2023-01-07]. ISSN 0305-1048. doi:10.1093/nar/gkt1069. PMID 24225321. (anglicky)
- ↑ a b HU, Youjia; ZHU, Baoquan. Study on genetic engineering of Acremonium chrysogenum , the cephalosporin C producer. Synthetic and Systems Biotechnology. 2016-09, roč. 1, čís. 3, s. 143–149. Dostupné online [cit. 2023-01-07]. doi:10.1016/j.synbio.2016.09.002. PMID 29062938. (anglicky)
- ↑ a b PÖGGELER, Stefanie; HOFF, Birgit; KÜCK, Ulrich. Asexual Cephalosporin C Producer Acremonium chrysogenum Carries a Functional Mating Type Locus. Applied and Environmental Microbiology. 2008-10, roč. 74, čís. 19, s. 6006–6016. Dostupné online [cit. 2023-01-07]. ISSN 0099-2240. doi:10.1128/AEM.01188-08. PMID 18689517. (anglicky)
- ↑ Jana Ambrožová: Encyklopedie hydrobiologie. 147.33.74.135 [online]. [cit. 2023-01-07]. Dostupné online.
- ↑ HOFF, Birgit; SCHMITT, Esther K.; KÜCK, Ulrich. CPCR1, but not its interacting transcription factor AcFKH1, controls fungal arthrospore formation in Acremonium chrysogenum: CPCR1 controls morphological differentiation in A. chrysogenum. Molecular Microbiology. 2005-03-30, roč. 56, čís. 5, s. 1220–1233. Dostupné online [cit. 2023-01-07]. doi:10.1111/j.1365-2958.2005.04626.x. (anglicky)
- ↑ NOVICKI, Thomas J.; LAFE, Karen; BUI, Lynda. Genetic Diversity among Clinical Isolates of Acremonium strictum Determined during an Investigation of a Fatal Mycosis. Journal of Clinical Microbiology. 2003-06, roč. 41, čís. 6, s. 2623–2628. Dostupné online [cit. 2023-01-07]. ISSN 0095-1137. doi:10.1128/JCM.41.6.2623-2628.2003. PMID 12791889. (anglicky)
- ↑ a b c d e f g cephalosporin | drug | Britannica. www.britannica.com [online]. [cit. 2023-01-07]. Dostupné online. (anglicky)
- ↑ a b c d e f g h i j k l m n KHAN, Nida Tabassum. Cephalosporin C Production from Acremonium chrysogenum. Enzyme Engineering. 2017, roč. 06, čís. 01. Dostupné online [cit. 2023-01-07]. ISSN 2329-6674. doi:10.4172/2329-6674.1000159.
- ↑ a b c d e f MARTÍN, Juan F; DEMAIN, Arnold L. Unraveling the methionine–cephalosporin puzzle in Acremonium chrysogenum. Trends in Biotechnology. 2002-12, roč. 20, čís. 12, s. 502–507. Dostupné online [cit. 2023-01-07]. doi:10.1016/S0167-7799(02)02070-X. (anglicky)
- ↑ a b c d e YANG, Yang; LU, Hua; DING, Ming-Zhu. Comparative analysis of intracellular metabolites of Cephalosporium acremonium in pilot and industrial fermentation processes. Biotechnology and Applied Biochemistry. 2012-05-01, roč. 59, čís. 3, s. 228–237. Dostupné online [cit. 2023-01-07]. doi:10.1002/bab.1019. (anglicky)
- ↑ LIRAS, Paloma; MARTÍN, Juan F. Gene clusters for beta-lactam antibiotics and control of their expression: why have clusters evolved, and from where did they originate?. International Microbiology: The Official Journal of the Spanish Society for Microbiology. 2006-03, roč. 9, čís. 1, s. 9–19. PMID: 16636985. Dostupné online [cit. 2023-01-07]. ISSN 1139-6709. PMID 16636985.
- ↑ CALTRIDER, P. G.; HUBER, F. M.; DAY, L. E. Effect of Methionine and Sulfate on the Metabolism of Cephalosporium acremonium. Applied Microbiology. 1968-12, roč. 16, čís. 12, s. 1913–1918. Dostupné online [cit. 2023-01-07]. ISSN 0003-6919. doi:10.1128/am.16.12.1913-1918.1968. PMID 16349829. (anglicky)
- ↑ BARTOSHEVICH, Yu. E.; ZASLAVSKAYA, P. L.; NOVAK, M. J. Acremonium chrysogenum differentiation and biosynthesis of cephalosporin. Journal of Basic Microbiology. 1990, roč. 30, čís. 5, s. 313–320. Dostupné online [cit. 2023-01-07]. doi:10.1002/jobm.3620300503. (anglicky)
- ↑ MARTIN, J F; DEMAIN, A L. Control of antibiotic biosynthesis. Microbiological Reviews. 1980-06, roč. 44, čís. 2, s. 230–251. Dostupné online [cit. 2023-01-07]. ISSN 0146-0749. doi:10.1128/mr.44.2.230-251.1980. PMID 6991900. (anglicky)
- ↑ DREW, Stephen W.; DEMAIN, Arnold L. Methionine control of cephalosporin C formation. Biotechnology and Bioengineering. 1973-07, roč. 15, čís. 4, s. 743–754. Dostupné online [cit. 2023-01-07]. ISSN 0006-3592. doi:10.1002/bit.260150408. (anglicky)
- ↑ KOMATSU, Ken-Ichi; MIZUNO, Masayuki; KODAIRA, Ryoji. Effect of methionine on cephalosporin C and penicillin N production by a mutant of Cephalosporium acremonium.. The Journal of Antibiotics. 1975, roč. 28, čís. 11, s. 881–888. Dostupné online [cit. 2023-01-07]. ISSN 0021-8820. doi:10.7164/antibiotics.28.881. (anglicky)
- ↑ VELASCO, Javier; LUIS ADRIO, José; ÁNGEL MORENO, Miguel. Environmentally safe production of 7-aminodeacetoxycephalosporanic acid (7-ADCA) using recombinant strains of Acremonium chrysogenum. Nature Biotechnology. 2000-08, roč. 18, čís. 8, s. 857–861. Dostupné online [cit. 2023-01-07]. ISSN 1087-0156. doi:10.1038/78467. (anglicky)
- ↑ DEMODENA, J. A.; GUTIÉRREZ, S.; VELASCO, J. The Production of Cephalosporin C by Acremonium chrysogenum is Improved by the Intracellular Expression of a Bacterial Hemoglobin. Nature Biotechnology. 1993-08, roč. 11, čís. 8, s. 926–929. Dostupné online [cit. 2023-01-07]. ISSN 1087-0156. doi:10.1038/nbt0893-926. (anglicky)
- ↑ ZHGUN, Alexander; DUMINA, Mariya; VALIAKHMETOV, Ayrat. The critical role of plasma membrane H+-ATPase activity in cephalosporin C biosynthesis of Acremonium chrysogenum. PLOS ONE. 31. 8. 2020, roč. 15, čís. 8, s. e0238452. Dostupné online [cit. 2023-01-07]. ISSN 1932-6203. doi:10.1371/journal.pone.0238452. PMID 32866191. (anglicky)
- ↑ GUNNARSSON, Nina; ELIASSON, Anna; NIELSEN, Jens. Control of Fluxes Towards Antibiotics and the Role of Primary Metabolism in Production of Antibiotics. Příprava vydání A. A. Brakhage. Svazek 88. Berlin, Heidelberg: Springer Berlin Heidelberg Dostupné online. ISBN 978-3-540-22032-9, ISBN 978-3-540-44406-0. doi:10.1007/b99260. S. 137–178. DOI: 10.1007/b99260.
- ↑ a b ZHOU, Weichang; HOLZHAUER-RIEGER, Karin; BAYER, Thomas. Cephalosporin C production by a highly productive Cephalosporium acremonium strain in an airlift tower loop reactor with static mixers. Journal of Biotechnology. 1993-04, roč. 28, čís. 2–3, s. 165–177. Dostupné online [cit. 2023-01-07]. doi:10.1016/0168-1656(93)90168-M. (anglicky)
- ↑ a b c ZAFIRA, Indira Zahra; NANDONG, Jobrun. Optimal feeding strategy of Cephalosporin C fermentation. IOP Conference Series: Materials Science and Engineering. 2019-06-07, roč. 495, s. 012107. Dostupné online [cit. 2023-01-07]. ISSN 1757-899X. doi:10.1088/1757-899X/495/1/012107.